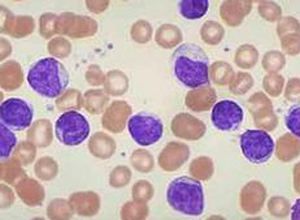
淋巴細胞活素 淋巴細胞活素

淋巴細胞活素(lymphokine)在細胞免疫方面,先前發生過致敏作用的淋巴細胞(主要是T細胞)再次與抗原相遇時釋放出可溶性物質的總稱。主要有遊走抑制因子,巨噬細胞活化因子(macrophageactivatingfactor),白細胞遊走因子(leucotacticfactor),皮膚反應因子(skinreactivefactor),細胞毒性因子(cytotoxicfactor),促有絲分裂因子(mitogenicfactor),DNA合成抑制因子等等。這些都是根據各別的機能方面命名的,因此少數物質顯示出一些機能的可能性是不能否定的。
相關詞條
-
細胞活素
細胞因子(Cytokine)是由免疫細胞或非免疫細胞合成和分泌的小分子多肽。天然免疫和特異性免疫的效應階段大部分是由細胞因子介導的。
概述 相關套用 -
抗人T淋巴細胞兔免疫球蛋白
抗人T淋巴細胞兔免疫球蛋白,免疫反應的抑制ATG-Fresenius S通常與其它免疫抑制劑藥(皮質激素,硫唑嘌呤或環胞菌素A等)聯合使用,抑制免疫系統...
成份 性狀 適應症 規格 用法用量 -
防禦素
防禦素是一類富含二硫鍵的陽離子型多肽,廣泛分布於真菌、植物與動物中,是生物免疫系統中的重要調節分子 ;此外,防禦素具有直接的殺菌功能,是一類重要的抗菌肽。
防禦素介紹 研究背景 防禦素的分類 生物活性 防禦素的套用 -
抗人淋巴細胞免疫球蛋白
抗人淋巴細胞豬免疫球蛋白 套用於人體免疫使用。
藥品名稱 使用說明 -
B淋巴細胞表面標誌
體液免疫功能檢測是實驗室估評個體體液免疫功能的一類檢驗。體液免疫功能檢測根據體液免疫的基本過程,包括B淋巴細胞檢測、Ig檢測以及抗體產生功能的檢測等。
正常值 臨床意義 注意事項 相關疾病 -
抑促濾泡素
生物化學產品,抑促濾泡素是人體內的一種激素。
-
多美素
多美素是石藥集團自主研發的首個抗腫瘤脂質體新藥,可用於低CD4(
多美素簡介 多美素說明書 多美素上市 -
信為番茄紅素軟膠囊
化學方式:番茄紅素可以和過氧化氫、二氧化氮等活性氧碎片直接反應,從而清除活性氧自由基。 番茄紅素對子宮癌細胞、乳腺癌細胞、肺癌細胞具有極強的抑制作用,其...